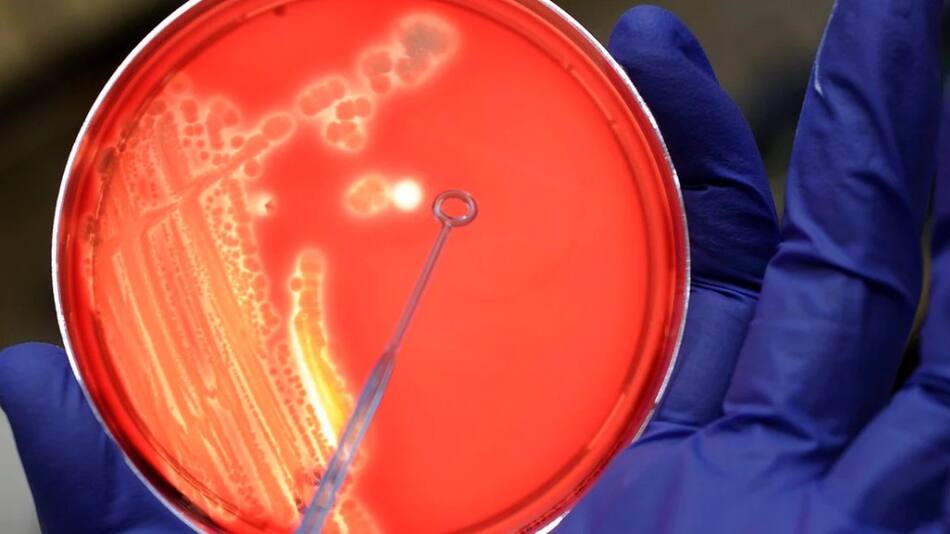

El síndrome urémico hemolítico, la enfermedad mortal que volvió a crecer en la Argentina
La enfermedad se produce por la ingesta de alimentos contaminados y afecta sobre todo a chicos. Volvió a presentarse con frecuencia luego de una década de mejoras.
El síndrome urémico hemolítico volvió a alertar a los especialistas luego de que la curva, que fue descendente en los últimos años, volviera a crecer con más casos en 2023 que en 2021 y 2022.
Los datos corresponden a las primeras 23 semanas de 2023 e indican que hubo 159 casos de SUH (126 en menores de 5 años), lo que significa una tasa de 0,34 cada 100 mil habitantes.
En 2021 a esta misma altura del año había 138 casos (tasa de 0,30) lo que lo transformó en el año con menor incidencia de la serie histórica. En 2020, para la misma altura del año se habían registrado 200 casos.
Detalles del SUH
Se trata es una enfermedad causada por la bacteria Escherichia coli, que se encuentra en el intestino de las vacas y otros animales de granja.
Se presenta con mayor frecuencia en chicos menores de 5 años, afecta especialmente los riñones y puede ser mortal.
Los picos se dan generalmente en primavera y verano, dado que el inicio de la época de calor es la más propicia para contraer la enfermedad en virtud de que la bacteria prolifera más en el ambiente.

La bacteria puede ingresar al organismo a través de las carnes poco cocidas (sobre todo carne picada), verduras crudas, leche o productos lácteos sin pasteurizar, contaminación cruzada (al usar la misma superficie o utensilios para lo crudo y lo cocido), agua no potable, manos contaminadas (contagio de persona a persona), y el baño con aguas contaminadas.
Los síntomas del SUH generalmente empiezan “con diarrea con presencia de sangre, dolores abdominales y vómitos. La persona también puede presentar palidez, alteración de la conciencia, disminución en la eliminación de orina, convulsiones y otros síntomas”, explica el Ministerio de Salud.



















